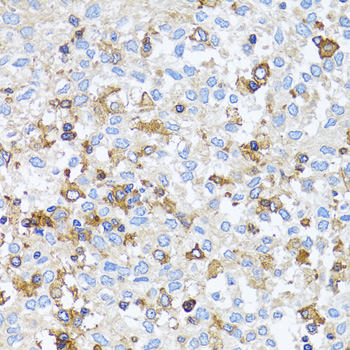
Immunohistochemistry - ACTR2 Polyclonal Antibody

-
Product Name
ACTR2 Polyclonal Antibody
- Documents
-
Description
Polyclonal antibody to ACTR2
-
Tested applications
WB, IHC, IF
-
Species reactivity
Human, Mouse, Rat
-
Alternative names
ACTR2 antibody; ARP2 antibody; actin-related protein 2 antibody
-
Isotype
Rabbit IgG
-
Preparation
Antigen: Recombinant fusion protein containing a sequence corresponding to amino acids 1-160 of human ACTR2 (NP_005713.1).
-
Clonality
Polyclonal
-
Formulation
PBS with 0.02% sodium azide, 50% glycerol, pH7.3.
-
Storage instructions
Store at -20℃. Avoid freeze / thaw cycles.
-
Applications
WB 1:500 - 1:2000
IHC 1:50 - 1:200
IF 1:50 - 1:200 -
Validations

Western blot - ACTR2 Polyclonal Antibody
Western blot analysis of extracts of various cell lines, using ACTR2 antibody at 1:1000 dilution.Secondary antibody: HRP Goat Anti-Rabbit IgG (H+L) at 1:10000 dilution.Lysates/proteins: 25ug per lane.Blocking buffer: 3% nonfat dry milk in TBST.Detection: ECL Basic Kit .Exposure time: 90s.

Western blot - ACTR2 Polyclonal Antibody
Western blot analysis of extracts of various cells, using ACTR2 antibody at 1:1000 dilution ratio through one-step method.Secondary antibody: HRP Goat Anti-Rabbit IgG (H+L) at 1:4000 dilution.Lysates/proteins: 25ug per lane.Blocking buffer: 3% nonfat dry milk in TBST.Detection: ECL Basic Kit .Exposure time: 90s.

Immunohistochemistry - ACTR2 Polyclonal Antibody
Immunohistochemistry of paraffin-embedded human liver cancer using ACTR2 antibody at dilution of 1:100 (40x lens).
Immunohistochemistry - ACTR2 Polyclonal Antibody
Immunohistochemistry of paraffin-embedded rat brain using ACTR2 antibody at dilution of 1:100 (40x lens).

Immunohistochemistry - ACTR2 Polyclonal Antibody
Immunohistochemistry of paraffin-embedded rat spleen using ACTR2 antibody at dilution of 1:100 (40x lens).

Immunohistochemistry - ACTR2 Polyclonal Antibody
Immunohistochemistry of paraffin-embedded human lung cancer using ACTR2 antibody at dilution of 1:100 (40x lens).

Immunohistochemistry - ACTR2 Polyclonal Antibody
Immunohistochemistry of paraffin-embedded human uterine cancer using ACTR2 antibody at dilution of 1:100 (40x lens).
-
Background
ATP-binding component of the Arp2/3 complex, a multiprotein complex that mediates actin polymerization upon stimulation by nucleation-promoting factor (NPF). The Arp2/3 complex mediates the formation of branched actin networks in the cytoplasm, providing the force for cell motility. Seems to contact the pointed end of the daughter actin filament. In addition to its role in the cytoplasmic cytoskeleton, the Arp2/3 complex also promotes actin polymerization in the nucleus, thereby regulating gene transcription and repair of damaged DNA. The Arp2/3 complex promotes homologous recombination (HR) repair in response to DNA damage by promoting nuclear actin polymerization, leading to drive motility of double-strand breaks (DSBs).
Related Products / Services
Please note: All products are "FOR RESEARCH USE ONLY AND ARE NOT INTENDED FOR DIAGNOSTIC OR THERAPEUTIC USE"
